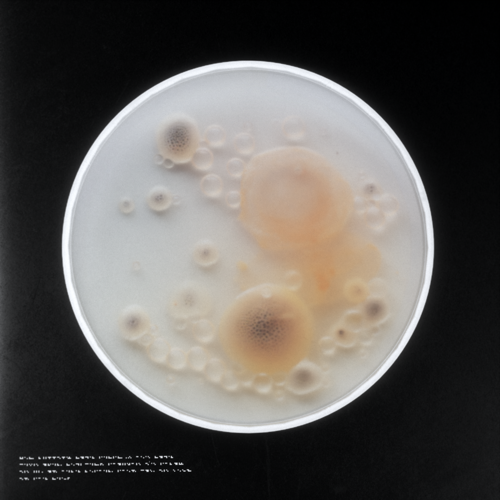
REF

JUNK MARKETPLACE

SELLER: ANON346346
DESCRIPTION: AN INTRODUCTION INTO MODDING UR FIRST MEMREE. *NOTE* THIS IS JUST BLUEPRINTS - ALL TRASH SCYTHES ETC MUST BE SOURCED URSELF.

SELLER: ANON32111
DESCRIPTION: LAST FEW OF THE BATCH. U KNOW THE DRILL… THE ENCRUSTED ALLOY SLOWLY CREEPS AROUND THE SHELL LIKE A BACTERIA COLONY.

SELLER: ANON32134
DESCRIPTION: EXPOSING YOUR REVIVED MEMREE EGG TO THIS THING SEEMS TO SPEED UP THE HATCHING PROCESS.

SELLER: ANON574890
DESCRIPTION: FOUND THIS PERFECT SPECIMEN AFTER A BIG EXTRA PUNGENT TIDAL EJECTION HIT THE BEACH. DON’T KNOW WHO OR WHAT CRAFTED THIS THING BUT IT’S EXPERTLY MADE.

SELLER: ANON432643
DESCRIPTION: WRETCHED GREEN METAL OOZE. UNSAFE MATERIAL FOR ANALYSIS ONLY!!! I THINK IT’S RESIDUE FROM THE ALGYUM’S SKIN??? TAKE THIS CR*P OFF MY HANDS.

SELLER: ANON32111
DESCRIPTION: THE METALLIC SUBSTANCE ON THIS SHELL WRIGGLES AND MOVES LIKE IT’S ALIVE. FOUND A MASSIVE BATCH OF THESE TODAY. SUPER ANCIENT PREMIUM JUNK.

SELLER: ANON32111
DESCRIPTION: THIS ONE ALMOST “BREATHES” THRU THOSE SORT OF METALLIC GILLS. THIS BATCH OF SHELLS IS THE OLDEST SH*T I’VE EVER FOUND. THIS EXTRA STRONG STORM IS STIRRING UP SOME VERY ARCHAIC STUFF.

SELLER: ANON45657
DESCRIPTION: LOOKS LIKE SOME KIND OF IMPRESSION OF A SLEEPING EMBRYO THING. IT’S QUITE SMALL & HAS SWIRLING AZURE TINTS. NEED BIG BUCKS FOR THIS ONE.

SELLER: ANON32111
DESCRIPTION: THIS ONE GIVES ME THE CREEPS TBH. PROBABLY A PART OF SOMETHIN LARGER. EXTREMELY HEAVY FOR IT’S SIZE.

SELLER: ANON574890
DESCRIPTION: SOMEHOW COMPLETELY UNTARNISHED BY TIME. CLEARLY THESE BEINGS WERE POPULAR IN WHATEVER TIME PERIOD ALL THIS NEW JUNK IS FROM. I’M NO HISTORIAN THO, CONTACT ME IF U HAVE BIG ¢$£¢$£¢$£ TO OFFER.

SELLER: ANON489023
DESCRIPTION: WEIRD LOOKING SCULPTURE I FOUND A FEW WEEKS AGO UNDERNEATH AN OIL RIG. DON’T REALLY WANT TO SELL THIS TBH BUT WILL PART WAYS WIV IT FOR A GOOD PRICE.

SELLER: ANON2547802
DESCRIPTION: EXTREMELY DAMAGED / POOR CONDITION. WILL PROBS BREAK IN TRANSIT SO BRING UR OWN BOX OR SOMETHING. NO REFUNDS. THESE SELL VERY FAST FOR SOME REASON. DON’T INQUIRE ABOUT ANY INFO (THAT ISN’T ABOUT CASH) COS I DON’T KNOW ANYTHING ABOUT THIS THING.
SELLER: ANON01998748
DESCRIPTION: WEIRD listing & I'M NOT TOO SURE IF THIS WILL SELL BUT WORTH A TRY. FOUND THIS GUY ON THE WESTERN COVES BY THE POWERLINES. THOUGHT IT WAS A HORSESHOE CRAB UNTIL I NOTICED IT WAS COVERED IN SOME KIND OF HARDENED MERCURY. SOMEONE BUY THIS SO I DON’T HAVE 2 LOOK AT IT ANYMORE.

SELLER: ANON33356
DESCRIPTION: CHIPPED OFF BLOCK OF A BIG MINERAL SLAB. IT HAS A PUNGENT SULPHURIC AROMA. POPULAR WITH MY WEIRDO CUSTOMERBASE WHO SEEM TO SCAN THIS STUFF FOR TRACES OF ‘DATA’ OR SOMETHING.

SELLER: ANON508389
DESCRIPTION: DECENT CONDITION TOOL. I KNOW THESE HAVE BEEN FOUND BY THE BOATLOAD RECENTLY BUT THIS ONE IS PARTICULARLY GOOD CONDITION. HEAVIER THAN IT LOOKS.

SELLER: ANON767843
DESCRIPTION: PRETTY SMALL BUT HAS AN INTERESTING MARKING. HAVEN’T DATED IT COS I DON’T BOTHER WITH THAT KIND OF SH*T. HAS A FAINT AZURE GLOW.

SELLER: ANON473890
DESCRIPTION: VERY BIZARRE GLASS-LIKE DISC. ONLY EVER FOUND TWO OF THESE BEFORE. A MATE OF MINE NOTICED THERE’S SOME KIND OF ANIMAL ENGRAVED ON IT. I NEED BIG CASH FOR THIS.

SELLER: ANON0091110
DESCRIPTION: LOOKS LIKE SOME KIND OF STRUCTURAL BEAM. IT’S MADE OF A SLIGHTLY METALLIC MATERIAL I DON’T REALLY RECOGNISE. MOST IMPORTANTLY HAS AN ENGRAVING OF SOMETHING. OPEN TO OFFERS. WARNING - THIS THING IS MASSIVE.
SELLER: ANON189503
DESCRIPTION: WAS RUNNING SOME TESTS & HAD SOME LEFT OVER SAMPLES. THOUGHT I’D THROW IT UP ON HERE RATHER THAN LOB IT BACK IN THE SEA.